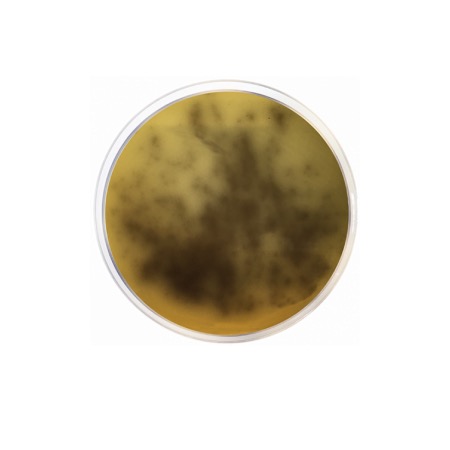
product

Brucella Agar is a culture medium designed for the cultivation of Brucella species. Due to its nutrient-rich formulation, it is also highly effective for the growth of other fastidious microorganisms, including Streptococcus pneumoniae, Listeria, and various anaerobic bacteria when appropriately supplemented.
Brucella Agar is an enriched medium that provides the demanding nutritional requirements of Brucella. It contains Casein Peptone and Meat Peptone, which supply organic nitrogen and amino acids, while Yeast Extract provides essential B-complex vitamins. Glucose is included as the primary energy source to enhance bacterial metabolism. The addition of Sodium Chloride maintains the osmotic equilibrium of the medium. When used for the isolation of Brucella from clinical or environmental samples, it is often supplemented with 5-10% sterile blood (horse or sheep) to further enrich the medium and allow for the observation of hemolytic reactions.
Advantages
- Highly Nutritious: Supports the growth of a wide range of fastidious pathogens beyond just Brucella species.
- Versatile Application: Serves as an excellent base for preparing blood agar or selective media with the addition of antibiotic supplements.
- Supports Anaerobes: When supplemented with Vitamin K1 and Hemin, it becomes an ideal medium for the isolation of anaerobic bacteria.
- Clear Observations: The clarity of the medium base allows for easy colonial morphology assessment.
- Standardized Quality: Formulated to ensure the reliable recovery of primary isolates from clinical specimens.
Technical specifications
| Catalogue number | 1012 |
| Brand | Condalab |
| Application | Cultivation of Brucella and fastidious microorganisms |
| Typical Composition (g/L) | Casein Peptone (10.0); Meat Peptone (10.0); Glucose (1.0); Yeast Extract (2.0); Sodium Chloride (5.0); Sodium Bisulfite (0.1); Bacteriological Agar (15.0) |
| Final pH (at 25 °C) | 7.0 ± 0.2 |
| Preparation | 43.1 g/L |
| Storage Temperature | 2 – 25 °C |
Available packaging options
| 1012 | 500 g plastic bottle |
| Brand | Condalab |
| Pack size | 500 g |